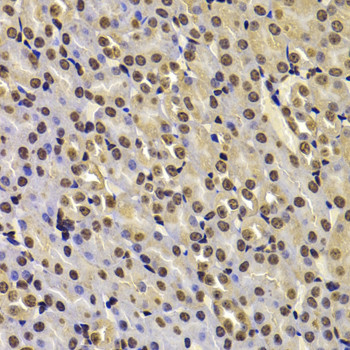
FBXW7 Antibody in Immunohistochemistry (Paraffin) (IHC (P))

Search
Invitrogen
FBXW7 Polyclonal Antibody
{{$productOrderCtrl.translations['antibody.pdp.commerceCard.promotion.promotions']}}
{{$productOrderCtrl.translations['antibody.pdp.commerceCard.promotion.viewpromo']}}
{{$productOrderCtrl.translations['antibody.pdp.commerceCard.promotion.promocode']}}: {{promo.promoCode}} {{promo.promoTitle}} {{promo.promoDescription}}. {{$productOrderCtrl.translations['antibody.pdp.commerceCard.promotion.learnmore']}}
图: 1 / 3
FBXW7 Antibody (PA5-120961) in IHC (P)



Please note: We are reviewing Western blot images included in the antibody testing data in our catalog, including those provided by third parties. Unless expressly labeled or annotated as “raw-unedited”, Western blot images included in the antibody testing data in our catalog may have been edited, optimized or otherwise adjusted for presentation.
产品信息
PA5-120961
种属反应
宿主/亚型
分类
类型
抗原
偶联物
形式
浓度
规格
纯化类型
保存液
内含物
保存条件
运输条件
RRID
产品详细信息
Positive test controls include: Jurkat, SH-SY5Y, MCF7, mouse testis, rat heart. The target is usually found in the following locations: Cytoplasm, Nucleus, nucleolus, nucleoplasm.
Immunogen sequence: PTGLQEWLKM FQSWSGPEKL LALDELIDSC EPTQVKHMMQ VIEPQFQRDF ISLLPKELAL YVLSFLEPKD LLQAAQTCRY WRILAEDNLL WREKCKEEGI DEPLHIKRRK VIKPGFIHSP WKSAYIRQHR IDTNWRRGEL K
靶标信息
F-Box and WD Repeat Domain Containing 7 (FBXW7) is a member of the F-box protein family which is characterized by an approximately 40 amino acid motif, the F-box. The F-box proteins constitute one of the four subunits of ubiquitin protein ligase complex called SCFs (SKP1-cullin-F-box), which function in phosphorylation-dependent ubiquitination. The F-box proteins are divided into 3 classes: Fbws containing WD-40 domains, Fbls containing leucine-rich repeats, and Fbxs containing either different protein-protein interaction modules or no recognizable motifs. FBXW7 was previously referred to as FBX30, and belongs to the Fbws class; in addition to an F-box, this protein contains 7 tandem WD40 repeats. This protein binds directly to cyclin E and probably targets cyclin E for ubiquitin-mediated degradation. Mutations in this gene are detected in ovarian and breast cancer cell lines, implicating the gene's potential role in the pathogenesis of human cancers. Multiple transcript variants encoding different isoforms have been found for this gene.
仅用于科研。不用于诊断过程。未经明确授权不得转售。
篇参考文献 (0)
生物信息学
蛋白别名: Archipelago homolog; DKFZp686F23254; F-box and WD repeat domain containing 7, E3 ubiquitin protein ligase; F-box and WD-40 domain protein 7; F-box and WD-40 domain protein 7, archipelago homolog; F-box and WD-40 domain-containing protein 7; f-box only protein 30; F-box protein FBW7; F-box protein FBX30; F-box protein Fbxw6; F-box-WD40 repeat protein 6; F-box/WD repeat-containing protein 7; FLJ11071; FLJ16457; hAgo; hCdc4; SEL-10
基因别名: 1110001A17Rik; AGO; Cdc4; FBW7; Fbwd6; FBX30; Fbxo30; Fbxw6; FBXW7; SEL-10; SEL10
UniProt ID: (Mouse) Q8VBV4, (Rat) D3Z902
Entrez Gene ID: (Mouse) 50754, (Rat) 100360914